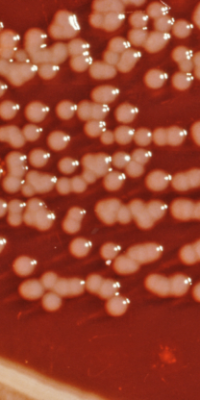
Yersinia_enterocolitica_01

Yersinia enterocolitica bacteria that causes infection by eating raw or undercooked pork. CDC estimates Y. enterocolitica causes almost 117,000 illnesses, 640 hospitalizations, and 35 deaths in the United States every year. The bacteria is spread through ingesting raw meat, unpasteurized milk, or untreated water.
Transmission:
The bacteria are most commonly cause infection through ingesting raw or undercooked meat. Drinking raw or unpasteurized milk or untreated water can also a significant threat. Practicing proper sanitation and hygiene through thorough hand washing after contact with animals or handling raw meat.
Symptoms:
The most common clinical manifestation of this infection is diarrhea and gastrointestinal distress. Symptoms typically develop 4 to 7 days after exposure and may last 1 to 3 weeks or longer. Other symptoms may include:
- Diarrhea, may be bloody in severe cases
- Low-grade fever
- Abdominal pain
- Vomiting